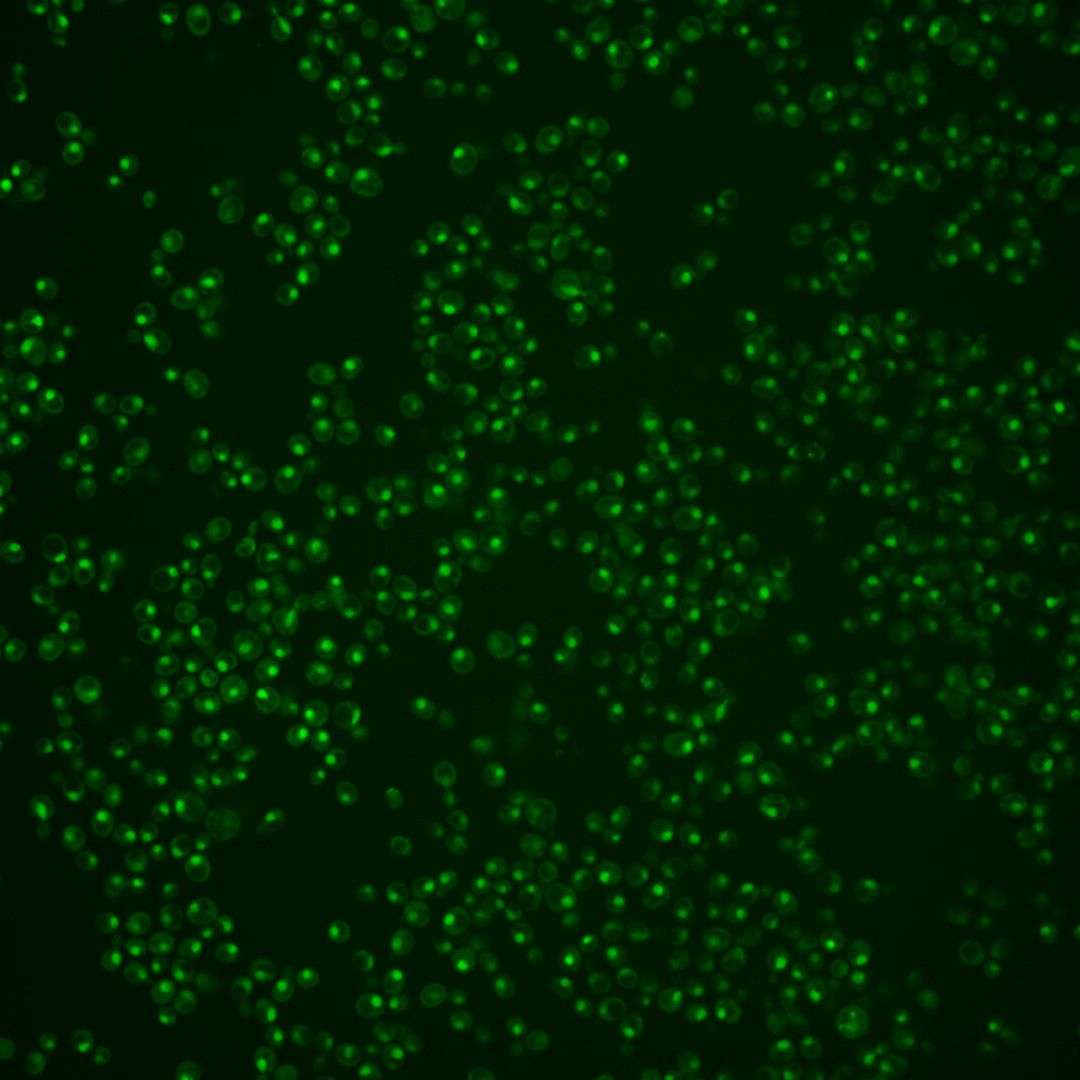
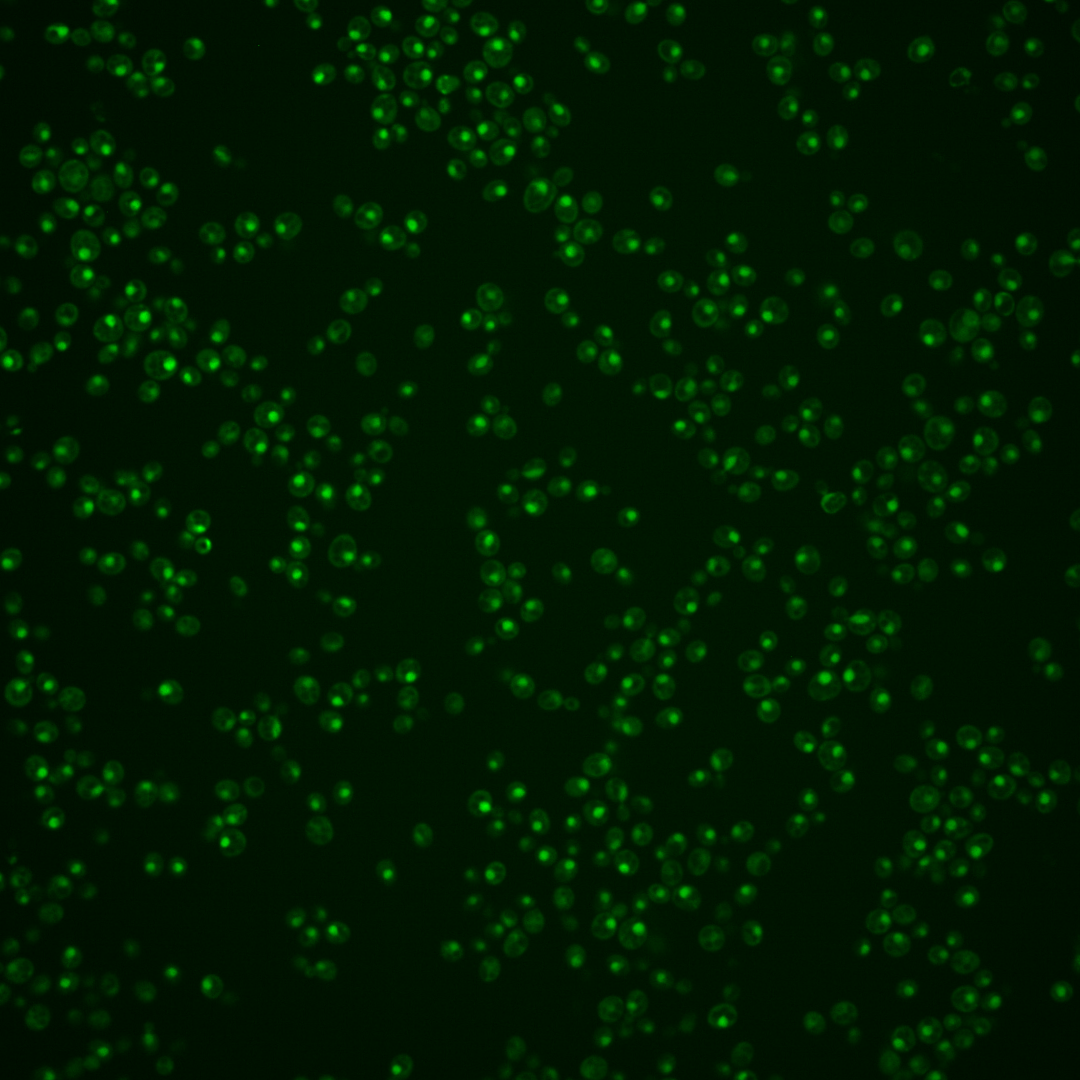
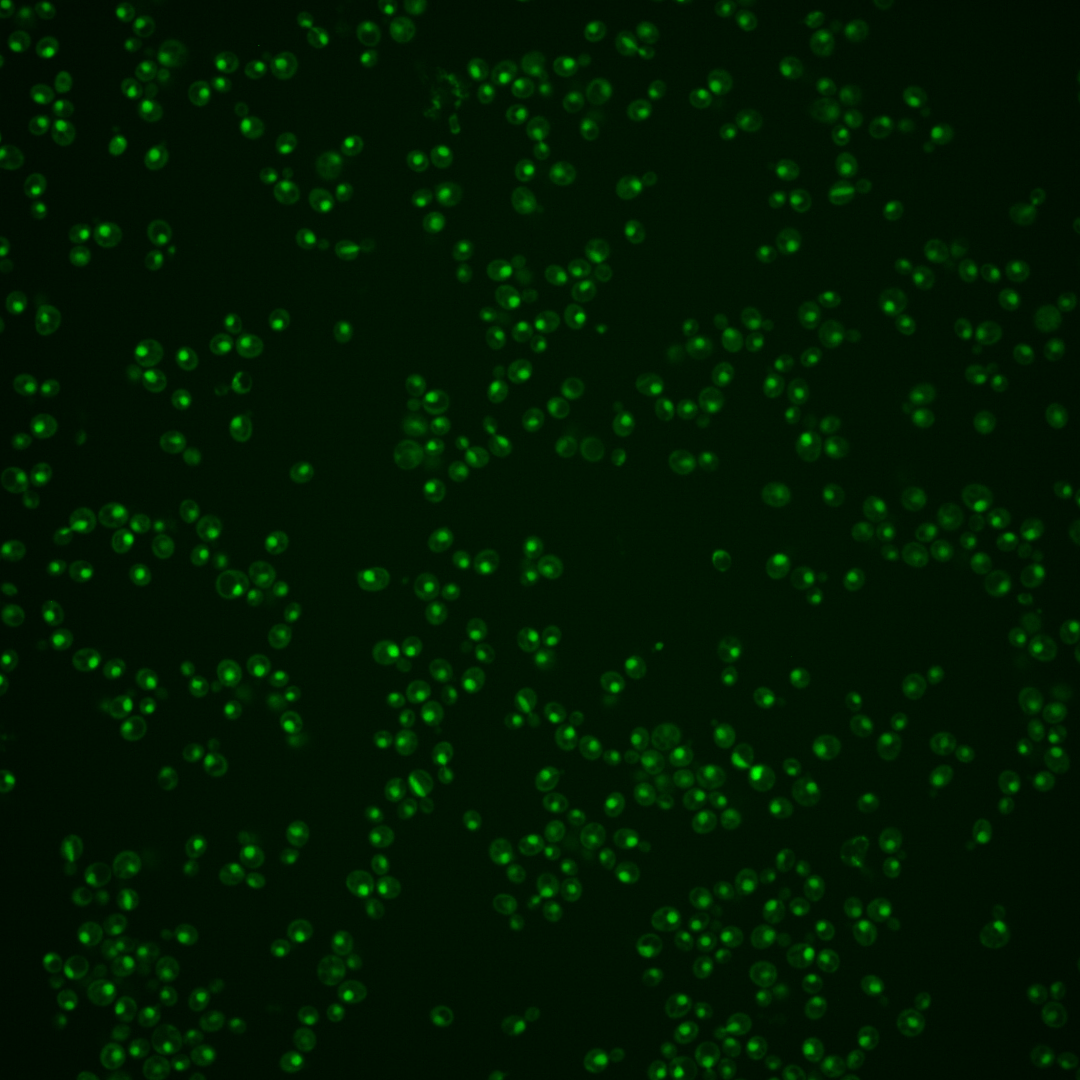

| Standard name | |
|---|---|
| Human Ortholog | |
| Description | Cyclin (Bur2p)-dependent protein kinase; part of the BUR kinase complex which functions in transcriptional regulation; phosphorylates the carboxy-terminal domain (CTD) of Rpo21p and the C-terminal repeat domain of Spt5p; recruits Spt6p to the CTD at the onset of transcription; regulated by Cak1p; similar to metazoan CDK9 proteins |
Micrographs




















































































Sub-cellular Localization
Yeast GFP Assignment
Protein Abundance
Localization Change
External localization resources
| ensLOC | DeepLoc | |||||||||||||||||||||||
|---|---|---|---|---|---|---|---|---|---|---|---|---|---|---|---|---|---|---|---|---|---|---|---|---|
| Localization | WT1 | WT2 | WT3 | RAP60 | RAP140 | RAP220 | RAP300 | RAP380 | RAP460 | RAP540 | RAP620 | RAP700 | HU80 | HU120 | HU160 | rpd3Δ_1 | rpd3Δ_2 | rpd3Δ_3 | WT1 | WT2 | WT3 | AF100 | AF140 | AF180 |
| Cortical Patches | 0 | 0 | 0 | 0 | 0 | 0 | 0 | 0 | 0 | 0 | 0 | 0 | 0 | 1 | 0 | 0 | 0 | 0 | 0 | 0 | 0 | 0 | 0 | 0 |
| Bud | 0 | 0 | 0 | 0 | 0 | 0 | 0 | 2 | 1 | 1 | 2 | 3 | 0 | 0 | 0 | 0 | 0 | 0 | 2 | 1 | 1 | 0 | 1 | 3 |
| Bud Neck | 0 | 0 | 0 | 0 | 0 | 0 | 0 | 0 | 0 | 1 | 0 | 0 | 0 | 0 | 0 | 0 | 0 | 0 | 0 | 0 | 0 | 0 | 0 | 0 |
| Bud Site | 0 | 0 | 0 | 0 | 0 | 1 | 1 | 1 | 2 | 6 | 2 | 6 | 0 | 0 | 0 | 0 | 0 | 0 | – | – | – | – | – | – |
| Cell Periphery | 0 | 0 | 0 | 0 | 0 | 0 | 0 | 0 | 0 | 0 | 0 | 0 | 0 | 0 | 0 | 0 | 2 | 1 | 0 | 0 | 0 | 0 | 0 | 0 |
| Cytoplasm | 4 | 7 | 0 | 3 | 19 | 13 | 15 | 23 | 16 | 13 | 12 | 9 | 8 | 16 | 34 | 16 | 43 | 24 | 0 | 0 | 0 | 0 | 4 | 2 |
| Endoplasmic Reticulum | 0 | 0 | 0 | 0 | 0 | 1 | 1 | 0 | 0 | 0 | 0 | 0 | 0 | 0 | 0 | 1 | 7 | 2 | 0 | 0 | 0 | 0 | 0 | 0 |
| Endosome | 1 | 1 | 1 | 0 | 0 | 1 | 0 | 1 | 0 | 0 | 0 | 1 | 0 | 0 | 1 | 1 | 3 | 6 | 0 | 1 | 0 | 0 | 3 | 1 |
| Golgi | 0 | 1 | 0 | 0 | 0 | 0 | 0 | 1 | 0 | 0 | 0 | 0 | 0 | 0 | 0 | 1 | 3 | 0 | 2 | 0 | 0 | 0 | 0 | 0 |
| Mitochondria | 12 | 2 | 1 | 0 | 1 | 10 | 24 | 14 | 38 | 47 | 68 | 53 | 1 | 0 | 1 | 9 | 6 | 8 | 2 | 2 | 0 | 0 | 1 | 2 |
| Nucleus | 312 | 203 | 63 | 165 | 246 | 284 | 459 | 511 | 270 | 364 | 318 | 346 | 84 | 211 | 215 | 230 | 490 | 362 | 308 | 202 | 72 | 51 | 210 | 293 |
| Nuclear Periphery | 6 | 0 | 0 | 0 | 1 | 0 | 3 | 0 | 0 | 3 | 0 | 4 | 0 | 0 | 1 | 0 | 1 | 1 | 0 | 0 | 0 | 0 | 0 | 1 |
| Nucleolus | 12 | 1 | 3 | 1 | 0 | 12 | 23 | 43 | 22 | 38 | 52 | 51 | 3 | 2 | 6 | 6 | 6 | 9 | 1 | 0 | 0 | 0 | 6 | 6 |
| Peroxisomes | 0 | 0 | 0 | 0 | 0 | 0 | 1 | 0 | 0 | 1 | 0 | 0 | 0 | 2 | 2 | 0 | 1 | 0 | 0 | 0 | 0 | 0 | 0 | 0 |
| SpindlePole | 0 | 0 | 0 | 0 | 1 | 0 | 2 | 4 | 1 | 2 | 1 | 1 | 0 | 3 | 3 | 0 | 2 | 0 | 2 | 0 | 0 | 0 | 4 | 2 |
| Vac/Vac Membrane | 3 | 5 | 1 | 2 | 2 | 2 | 6 | 3 | 4 | 5 | 2 | 1 | 0 | 4 | 2 | 8 | 16 | 19 | 5 | 4 | 2 | 0 | 22 | 33 |
| Unique Cell Count | 326 | 215 | 68 | 170 | 265 | 309 | 503 | 562 | 313 | 423 | 377 | 397 | 96 | 232 | 255 | 261 | 563 | 413 | 325 | 217 | 81 | 54 | 257 | 351 |
| Labelled Cell Count | 350 | 220 | 69 | 171 | 270 | 324 | 535 | 603 | 354 | 481 | 457 | 475 | 96 | 239 | 265 | 272 | 580 | 432 | 325 | 217 | 81 | 54 | 257 | 351 |
Yeast GFP Assignment
Protein Abundance
| Screen | WT1 | WT2 | WT3 | RAP60 | RAP140 | RAP220 | RAP300 | RAP380 | RAP460 | RAP540 | RAP620 | RAP700 | HU80 | HU120 | HU160 | rpd3Δ_1 | rpd3Δ_2 | rpd3Δ_3 | AF100 | AF140 | AF180 |
|---|---|---|---|---|---|---|---|---|---|---|---|---|---|---|---|---|---|---|---|---|---|
| Mean Cell GFP Intensity (1e-4) | 6.9 | 8.5 | 7.7 | 8.1 | 8.4 | 6.9 | 6.9 | 7.0 | 6.2 | 6.2 | 5.8 | 5.8 | 8.4 | 8.9 | 8.6 | 10.8 | 11.2 | 9.6 | 6.9 | 8.3 | 8.6 |
| Std Deviation (1e-4) | 4.8 | 1.3 | 1.3 | 1.3 | 1.4 | 1.2 | 1.5 | 1.6 | 1.7 | 1.5 | 1.5 | 1.4 | 1.9 | 1.8 | 1.9 | 2.4 | 2.6 | 2.3 | 0.7 | 1.4 | 1.3 |
| Intensity Change (Log2) | – | – | – | 0.08 | 0.13 | -0.14 | -0.16 | -0.14 | -0.31 | -0.3 | -0.4 | -0.41 | 0.13 | 0.21 | 0.17 | 0.5 | 0.54 | 0.32 | -0.16 | 0.11 | 0.17 |
Localization Change
| Localization | RAP60 | RAP140 | RAP220 | RAP300 | RAP380 | RAP460 | RAP540 | RAP620 | RAP700 | HU80 | HU120 | HU160 | rpd3Δ_1 | rpd3Δ_2 | rpd3Δ_3 |
|---|---|---|---|---|---|---|---|---|---|---|---|---|---|---|---|
| Cortical Patches | 0 | 0 | 0 | 0 | 0 | 0 | 0 | 0 | 0 | 0 | 0 | 0 | 0 | 0 | 0 |
| Bud | 0 | 0 | 0 | 0 | 0 | 0 | 0 | 0 | 0 | 0 | 0 | 0 | 0 | 0 | 0 |
| Bud Neck | 0 | 0 | 0 | 0 | 0 | 0 | 0 | 0 | 0 | 0 | 0 | 0 | 0 | 0 | 0 |
| Bud Site | 0 | 0 | 0 | 0 | 0 | 0 | 0 | 0 | 0 | 0 | 0 | 0 | 0 | 0 | 0 |
| Cell Periphery | 0 | 0 | 0 | 0 | 0 | 0 | 0 | 0 | 0 | 0 | 0 | 0 | 0 | 0 | 0 |
| Cytoplasm | 0 | 0 | 0 | 0 | 0 | 0 | 0 | 0 | 0 | 0 | 0 | 3.2 | 0 | 0 | 0 |
| Endoplasmic Reticulum | 0 | 0 | 0 | 0 | 0 | 0 | 0 | 0 | 0 | 0 | 0 | 0 | 0 | 0 | 0 |
| Endosome | 0 | 0 | 0 | 0 | 0 | 0 | 0 | 0 | 0 | 0 | 0 | 0 | 0 | 0 | 0 |
| Golgi | 0 | 0 | 0 | 0 | 0 | 0 | 0 | 0 | 0 | 0 | 0 | 0 | 0 | 0 | 0 |
| Mitochondria | 0 | 0 | 0 | 0 | 0 | 2.6 | 2.5 | 3.5 | 2.8 | 0 | 0 | 0 | 0 | 0 | 0 |
| Nucleus | 1.5 | 0.1 | -0.2 | -0.4 | -0.5 | -1.4 | -1.5 | -1.8 | -1.3 | -1.1 | -0.4 | -1.8 | -1.1 | -1.3 | -1.2 |
| Nuclear Periphery | 0 | 0 | 0 | 0 | 0 | 0 | 0 | 0 | 0 | 0 | 0 | 0 | 0 | 0 | 0 |
| Nucleolus | 0 | 0 | 0 | 0 | 0 | 0 | 1.3 | 2.2 | 2.0 | 0 | 0 | 0 | 0 | 0 | 0 |
| Peroxisomes | 0 | 0 | 0 | 0 | 0 | 0 | 0 | 0 | 0 | 0 | 0 | 0 | 0 | 0 | 0 |
| SpindlePole | 0 | 0 | 0 | 0 | 0 | 0 | 0 | 0 | 0 | 0 | 0 | 0 | 0 | 0 | 0 |
| Vacuole | 0 | 0 | 0 | 0 | 0 | 0 | 0 | 0 | 0 | 0 | 0 | 0 | 0 | 0 | 0 |
External localization resources
Images






























Protein Concentration and Protein Localization Data
| R1 | R2 | R3 | ||||||||||||||||
|---|---|---|---|---|---|---|---|---|---|---|---|---|---|---|---|---|---|---|
| G1 Pre-START | G1 Post-START | S/G2 | Metaphase | Anaphase | Telophase | G1 Pre-START | G1 Post-START | S/G2 | Metaphase | Anaphase | Telophase | G1 Pre-START | G1 Post-START | S/G2 | Metaphase | Anaphase | Telophase | |
| Concentration | 4.2139 | 5.0967 | 4.1487 | 4.0772 | 3.5131 | 4.0653 | 5.2153 | 5.7332 | 5.1859 | 4.6317 | 4.1267 | 4.908 | 2.867 | 3.3561 | 2.9317 | 2.5931 | 2.2866 | 2.6565 |
| Actin | 0.0183 | 0 | 0.0082 | 0.0357 | 0.0254 | 0.0026 | 0.0234 | 0 | 0.0005 | 0.0016 | 0 | 0.0054 | 0.0246 | 0 | 0.0004 | 0 | 0.0229 | 0 |
| Bud | 0.0013 | 0 | 0.0004 | 0.0009 | 0.0021 | 0.0001 | 0.0005 | 0 | 0 | 0.0001 | 0 | 0.0001 | 0.0002 | 0 | 0.0002 | 0 | 0.0002 | 0.0001 |
| Bud Neck | 0.0031 | 0 | 0.0027 | 0.0018 | 0.0028 | 0.0008 | 0.0004 | 0 | 0.0001 | 0.0003 | 0.0002 | 0.0005 | 0.0008 | 0 | 0.0004 | 0 | 0.0008 | 0.0005 |
| Bud Periphery | 0.0023 | 0 | 0.0009 | 0.0018 | 0.007 | 0.0001 | 0.0009 | 0 | 0 | 0.0001 | 0.0001 | 0.0001 | 0.0002 | 0 | 0.0004 | 0 | 0.0005 | 0.0002 |
| Bud Site | 0.0083 | 0 | 0.0074 | 0.0028 | 0.0041 | 0.0001 | 0.0027 | 0 | 0.0002 | 0.0004 | 0.0001 | 0.0001 | 0.0006 | 0 | 0.0006 | 0 | 0.0011 | 0 |
| Cell Periphery | 0.0005 | 0 | 0.0005 | 0.0003 | 0.0013 | 0 | 0.0001 | 0 | 0 | 0.0001 | 0 | 0 | 0.0001 | 0 | 0.0001 | 0 | 0.0002 | 0 |
| Cytoplasm | 0.0061 | 0.0001 | 0.0007 | 0.0003 | 0.0014 | 0.0001 | 0.0042 | 0.0001 | 0.0003 | 0.0017 | 0.0001 | 0.0001 | 0.0042 | 0 | 0.0015 | 0 | 0.0008 | 0 |
| Cytoplasmic Foci | 0.0164 | 0.0002 | 0.0108 | 0.0017 | 0.0047 | 0.0004 | 0.0212 | 0 | 0.002 | 0.0122 | 0.0165 | 0.0001 | 0.0055 | 0 | 0.0001 | 0 | 0.0018 | 0 |
| Eisosomes | 0.0002 | 0 | 0.0002 | 0.0013 | 0.0005 | 0 | 0.0002 | 0 | 0 | 0 | 0 | 0.0001 | 0.0003 | 0 | 0 | 0 | 0.0006 | 0 |
| Endoplasmic Reticulum | 0.0106 | 0.0001 | 0.0006 | 0.0006 | 0.0025 | 0.0003 | 0.002 | 0 | 0.0002 | 0.0011 | 0 | 0.0007 | 0.0068 | 0 | 0.0009 | 0 | 0.0005 | 0 |
| Endosome | 0.0359 | 0.0008 | 0.0104 | 0.0035 | 0.0151 | 0.0034 | 0.0111 | 0 | 0.0146 | 0.0172 | 0.0032 | 0.0013 | 0.0186 | 0 | 0.0004 | 0 | 0.0033 | 0 |
| Golgi | 0.0072 | 0.0001 | 0.0054 | 0.0053 | 0.0091 | 0.002 | 0.0028 | 0 | 0.0021 | 0.0058 | 0.0012 | 0.0012 | 0.004 | 0 | 0 | 0 | 0.0029 | 0 |
| Lipid Particles | 0.0176 | 0.0008 | 0.017 | 0.0068 | 0.027 | 0.002 | 0.0044 | 0 | 0.0007 | 0.0192 | 0.0192 | 0.0002 | 0.0055 | 0 | 0 | 0 | 0.0102 | 0 |
| Mitochondria | 0.0319 | 0.0001 | 0.0103 | 0.0225 | 0.0507 | 0.0071 | 0.0059 | 0.0001 | 0.0005 | 0.0022 | 0.0004 | 0.0011 | 0.0015 | 0.0001 | 0.0008 | 0.0001 | 0.0081 | 0.0008 |
| None | 0.0046 | 0.0001 | 0.0004 | 0.0006 | 0.0011 | 0.0001 | 0.0025 | 0 | 0.0002 | 0.0006 | 0 | 0 | 0.005 | 0 | 0.0001 | 0 | 0.0017 | 0 |
| Nuclear Periphery | 0.0258 | 0.0027 | 0.0026 | 0.0036 | 0.0353 | 0.0025 | 0.0254 | 0.0005 | 0.0003 | 0.0052 | 0.0012 | 0.0006 | 0.0146 | 0.0003 | 0.0031 | 0.0003 | 0.004 | 0.0002 |
| Nucleolus | 0.0203 | 0.0068 | 0.0137 | 0.0098 | 0.0661 | 0.0314 | 0.0075 | 0.0043 | 0.0029 | 0.0048 | 0.0554 | 0.019 | 0.0087 | 0.0045 | 0.0071 | 0.0042 | 0.0627 | 0.0201 |
| Nucleus | 0.734 | 0.9862 | 0.8954 | 0.8927 | 0.6987 | 0.9445 | 0.8627 | 0.9917 | 0.9739 | 0.89 | 0.8947 | 0.9691 | 0.8893 | 0.9949 | 0.9825 | 0.9953 | 0.8685 | 0.9777 |
| Peroxisomes | 0.0172 | 0 | 0.0031 | 0.0036 | 0.026 | 0.0002 | 0.0035 | 0 | 0.0004 | 0.0029 | 0.0047 | 0 | 0.0007 | 0 | 0 | 0 | 0.0048 | 0 |
| Punctate Nuclear | 0.0209 | 0.0016 | 0.0019 | 0.0015 | 0.0055 | 0.0017 | 0.0074 | 0.0034 | 0.0001 | 0.0115 | 0.0025 | 0.0001 | 0.0069 | 0 | 0.0004 | 0 | 0.0026 | 0.0001 |
| Vacuole | 0.0126 | 0.0002 | 0.0043 | 0.0014 | 0.01 | 0.0002 | 0.0034 | 0 | 0.0006 | 0.0111 | 0.0002 | 0.0001 | 0.0012 | 0.0001 | 0.0008 | 0 | 0.0008 | 0.0001 |
| Vacuole Periphery | 0.0049 | 0.0001 | 0.0034 | 0.0014 | 0.0038 | 0.0002 | 0.0076 | 0 | 0.0003 | 0.0119 | 0.0001 | 0.0001 | 0.0009 | 0 | 0.0002 | 0 | 0.0008 | 0.0001 |
Sequencing Data
| R1 | R2 | |||||||||
|---|---|---|---|---|---|---|---|---|---|---|
| G1 Post-START | S/G2 | Metaphase | Anaphase | Telophase | G1 Post-START | S/G2 | Metaphase | Anaphase | Telophase | |
| Gene Expression | 27.669 | 26.4833 | 21.1349 | 36.4586 | 21.3795 | 15.0838 | 27.1561 | 27.7912 | 27.0556 | 31.6195 |
| Translational Efficiency | 0.7707 | 0.9972 | 1.1885 | 0.7213 | 1.0446 | 1.2477 | 1.0106 | 0.8168 | 0.917 | 0.76 |
Hit Data
| Dataset | Hit |
|---|---|
| Protein Concentration | ✔ |
| Protein Localization | ✘ |
| Gene Expression | ✘ |
| Translational Efficiency | ✘ |
Endocytosis
| Temp | Actin Patch (Sac6-tdTomato) | Cortical Patch (Sla1-GFP) | Late Endosome (Snf7-GFP) | Vacuole (Vph1-GFP) |
|---|---|---|---|---|
| 37℃ | ||||
| RT |
Cell Cycle Omics
CYCLoPs (Sgv1-GFP)
| Gene / Allele | Actin Patch (Sac6-tdTomato) | Cortical Patch (Sla1-GFP) | Late Endosome (Snf7-GFP) | Vacuole (Sac6-tdTomato) |
|---|
| Gene | Images |
|---|
| Gene | Images |
|---|
Images are not yet available
Images are not yet available